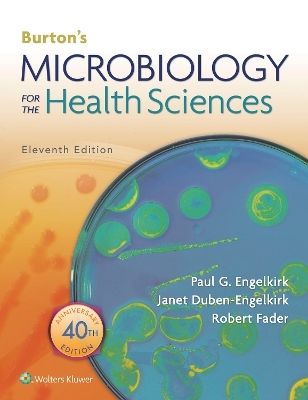
Burton's Microbiology for the Health Sciences - Paul Engelkirk, Janet Duben-Engelkirk, Robert Fader

Burton's Microbiology for the Health Sciences
Seiten
2018
|
Eleventh, North American Edition
Jones and Bartlett Publishers, Inc (Verlag)
978-1-4963-8046-3 (ISBN)
Jones and Bartlett Publishers, Inc (Verlag)
978-1-4963-8046-3 (ISBN)
- Titel erscheint in neuer Auflage
- Artikel merken
Zu diesem Artikel existiert eine Nachauflage
This fully updated 11th Edition of Burton’s Microbiology for the Health Sciences remains the only microbiology text written specifically for the Allied Health/Nursing Introductory Microbiology course as outlined by the American Society for Microbiology. Emphasizing the relevance of microbiology to a career in the health professions, the book provides the vital microbiology information students need to protect themselves and their patients from infectious diseases.
Enhanced by the expertise of a new lead author, the 11th Edition maintains its student friendly approach while adding new animations and videos and up-to-date coverage of key topics. For the first time, the PrepU adaptive quizzing program proven to improve student’s course mastery, is available for purchase to accompany the book.
NEW lead author Dr. Robert Fader, pathologist and microbiology/virology chief in the Baylor Scott & White Hospital System and assistant professor of pathology at the Texas A&M Health Science Center College of Medicine, brings his expertise to the 11th Edition.
NEW and expanded coverage includes the latest information on Ebola and Zika viruses, C-Diff, epidemic and pandemic viruses, specimen collection and lab procedures for identification of pathogens, the significance of the human microbiome on human health and development, and health care -associated infections caused by multi-drug resistant organisms.
NEW! More than 24 online animations and videos help students master difficult concepts.
More than 50 Study Aid boxes summarize key information, explain difficult concepts and differentiate similar-sounding terms.
Clinical Procedure boxes provide step-by-step instructions for common procedures critical in entry-level positions.
Self-Assessment Exercises help students gauge their understanding of what they have learned.
Historical Notes boxes provide insights into the development of microbiology.Something to Think About boxes encourage students to ponder interesting possibilities in health care.
In-text learning aids include chapter outlines, learning objectives, highlighted key points, and an end-of-book glossary.
Expanded online resources, including new critical thinking questions, give students unlimited opportunities for practice and review.
eBook available for purchase. Fast, smart, and convenient, today’s eBooks can transform learning. These interactive, fully searchable tools offer 24/7 access on multiple devices, the ability to highlight and share notes, and more
Enhanced by the expertise of a new lead author, the 11th Edition maintains its student friendly approach while adding new animations and videos and up-to-date coverage of key topics. For the first time, the PrepU adaptive quizzing program proven to improve student’s course mastery, is available for purchase to accompany the book.
NEW lead author Dr. Robert Fader, pathologist and microbiology/virology chief in the Baylor Scott & White Hospital System and assistant professor of pathology at the Texas A&M Health Science Center College of Medicine, brings his expertise to the 11th Edition.
NEW and expanded coverage includes the latest information on Ebola and Zika viruses, C-Diff, epidemic and pandemic viruses, specimen collection and lab procedures for identification of pathogens, the significance of the human microbiome on human health and development, and health care -associated infections caused by multi-drug resistant organisms.
NEW! More than 24 online animations and videos help students master difficult concepts.
More than 50 Study Aid boxes summarize key information, explain difficult concepts and differentiate similar-sounding terms.
Clinical Procedure boxes provide step-by-step instructions for common procedures critical in entry-level positions.
Self-Assessment Exercises help students gauge their understanding of what they have learned.
Historical Notes boxes provide insights into the development of microbiology.Something to Think About boxes encourage students to ponder interesting possibilities in health care.
In-text learning aids include chapter outlines, learning objectives, highlighted key points, and an end-of-book glossary.
Expanded online resources, including new critical thinking questions, give students unlimited opportunities for practice and review.
eBook available for purchase. Fast, smart, and convenient, today’s eBooks can transform learning. These interactive, fully searchable tools offer 24/7 access on multiple devices, the ability to highlight and share notes, and more
Microbiology Consultant and Co-FounderBiomedical Educational Services (Biomed Ed)Round Rock, Texas
| Erscheinungsdatum | 16.11.2019 |
|---|---|
| Verlagsort | Sudbury |
| Sprache | englisch |
| Maße | 213 x 276 mm |
| Gewicht | 1066 g |
| Themenwelt | Medizin / Pharmazie ► Medizinische Fachgebiete ► Mikrobiologie / Infektologie / Reisemedizin |
| ISBN-10 | 1-4963-8046-0 / 1496380460 |
| ISBN-13 | 978-1-4963-8046-3 / 9781496380463 |
| Zustand | Neuware |
| Informationen gemäß Produktsicherheitsverordnung (GPSR) | |
| Haben Sie eine Frage zum Produkt? |
Mehr entdecken
aus dem Bereich
aus dem Bereich
und Erste Hilfe an Bord
Buch | Softcover (2024)
MWV Medizinisch Wissenschaftliche Verlagsgesellschaft
CHF 55,90



